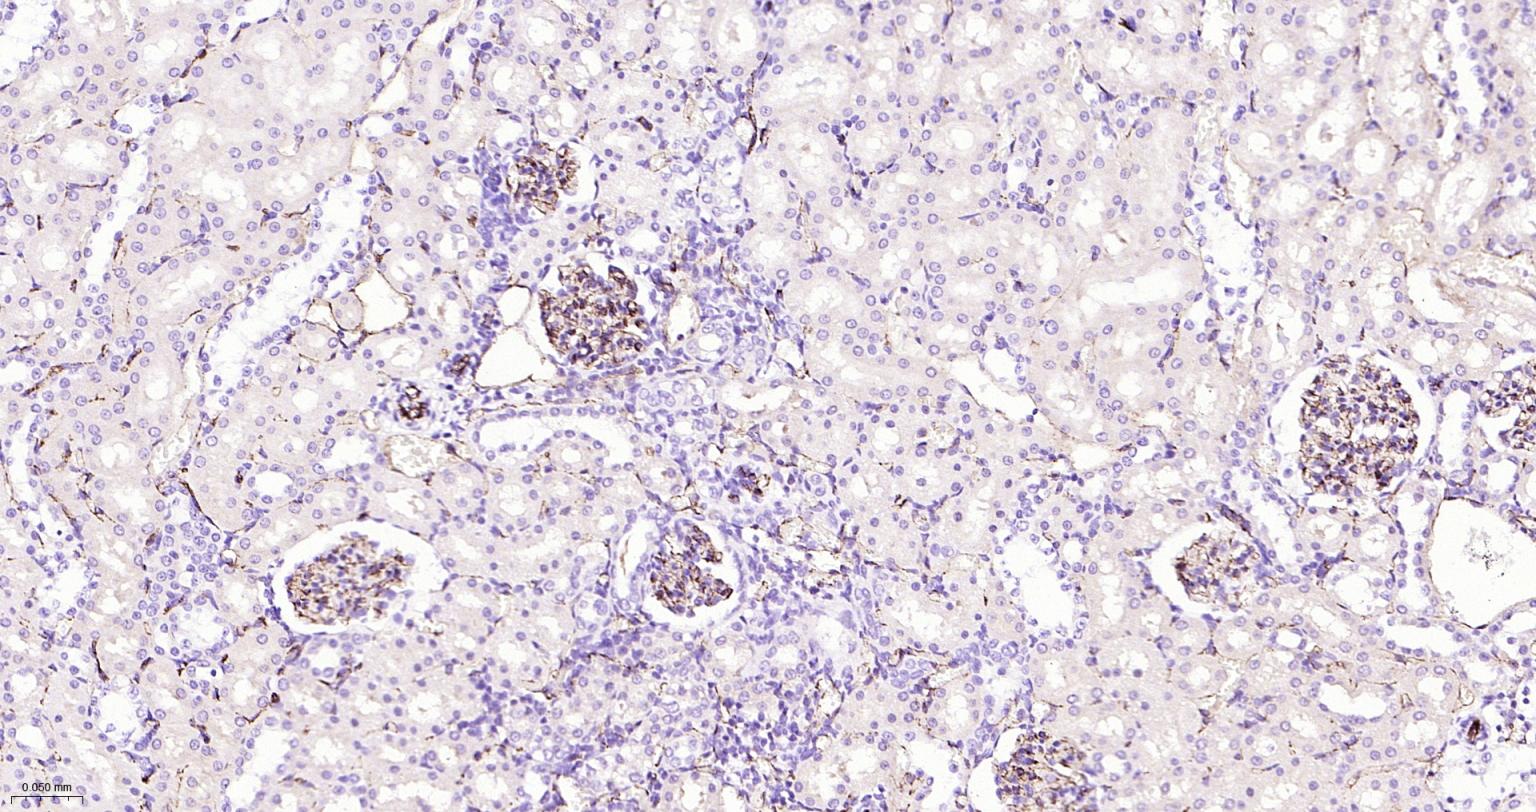
血小板内皮细胞黏附分子-1抗体

血小板内皮细胞黏附分子-1抗体

概述

产品应用
| 应用 | 已检合格种属 | 预测种属 | 推荐稀释比例 |
|---|---|---|---|
| IHC-P | Mouse, Rat | 1:200-500 | |
| IHC-F | Mouse, Rat | 1:200-500 | |
| IF | Mouse, Rat | 1:200-500 |
交叉反应
交叉反应: Mouse, Rat
相关产品
暂无相关产品
靶标
Trans-homodimer (via Ig-like C2-type 1 and Ig-like C2-type 2 domains); trans-homodimerization is required for cell-cell interaction (PubMed:26702061, PubMed:27958302).
Forms a complex with BDKRB2 and GNAQ (PubMed:18672896).
Interacts with BDKRB2 and GNAQ (PubMed:18672896).Interacts with PTPN11; Tyr-713 is critical for PTPN11 recruitment (PubMed:18388311, PubMed:19342684).
Interacts with FER (By similarity).
Interacts (via Ig-like C2-type domain 6) with CD177; the interaction is Ca2+-dependent; the interaction is direct (PubMed:17580308).
Isoform Long: Membrane; Single-pass type I membrane protein. Cell junction. Note=Localizes to the lateral border recycling compartment (LBRC) and recycles from the LBRC to the junction in resting endothelial cells.Isoform Delta15: Cell junction. Note=Localizes to the lateral border recycling compartment (LBRC) and recycles from the LBRC to the junction in resting endothelial cells.
Expressed on platelets and leukocytes and is primarily concentrated at the borders between endothelial cells (PubMed:18388311, PubMed:21464369).
Expressed in human umbilical vein endothelial cells (HUVECs) (at protein level) (PubMed:19342684, PubMed:17580308).
Expressed on neutrophils (at protein level) (PubMed:17580308).
Isoform Long predominates in all tissues examined (PubMed:12433657).
Isoform Delta12 is detected only in trachea (PubMed:12433657).
Isoform Delta14-15 is only detected in lung (PubMed:12433657).
Isoform Delta14 is detected in all tissues examined with the strongest expression in heart (PubMed:12433657).
Isoform Delta15 is expressed in brain, testis, ovary, cell surface of platelets, human umbilical vein endothelial cells (HUVECs), Jurkat T-cell leukemia, human erythroleukemia (HEL) and U-937 histiocytic lymphoma cell lines (at protein level) (PubMed:12433657, PubMed:18388311).
Phosphorylated on Ser and Tyr residues after cellular activation. Phosphorylated on tyrosine residues by FER and FES in response to FCER1 activation. In endothelial cells Fyn mediates mechanical-force (stretch or pull) induced tyrosine phosphorylation.
Contains 6 Ig-like C2-type (immunoglobulin-like) domains.
Cell adhesion molecule which is required for leukocyte transendothelial migration (TEM) under most inflammatory conditions (PubMed:19342684, PubMed:17580308).
Tyr-690 plays a critical role in TEM and is required for efficient trafficking of PECAM1 to and from the lateral border recycling compartment (LBRC) and is also essential for the LBRC membrane to be targeted around migrating leukocytes (PubMed:19342684).
Trans-homophilic interaction may play a role in endothelial cell-cell adhesion via cell junctions (PubMed:27958302).
Heterophilic interaction with CD177 plays a role in transendothelial migration of neutrophils (PubMed:17580308).
Homophilic ligation of PECAM1 prevents macrophage-mediated phagocytosis of neighboring viable leukocytes by transmitting a detachment signal (PubMed:12110892).
Promotes macrophage-mediated phagocytosis of apoptotic leukocytes by tethering them to the phagocytic cells; PECAM1-mediated detachment signal appears to be disabled in apoptotic leukocytes (PubMed:12110892).
Modulates bradykinin receptor BDKRB2 activation (PubMed:18672896).
Regulates bradykinin- and hyperosmotic shock-induced ERK1/2 activation in endothelial cells (PubMed:18672896).
Induces susceptibility to atherosclerosis (By similarity).
标记抗体
暂无标记数据
同靶标产品
暂无同靶标产品
相关文献
暂无相关文献
常见问题
暂无常见问题